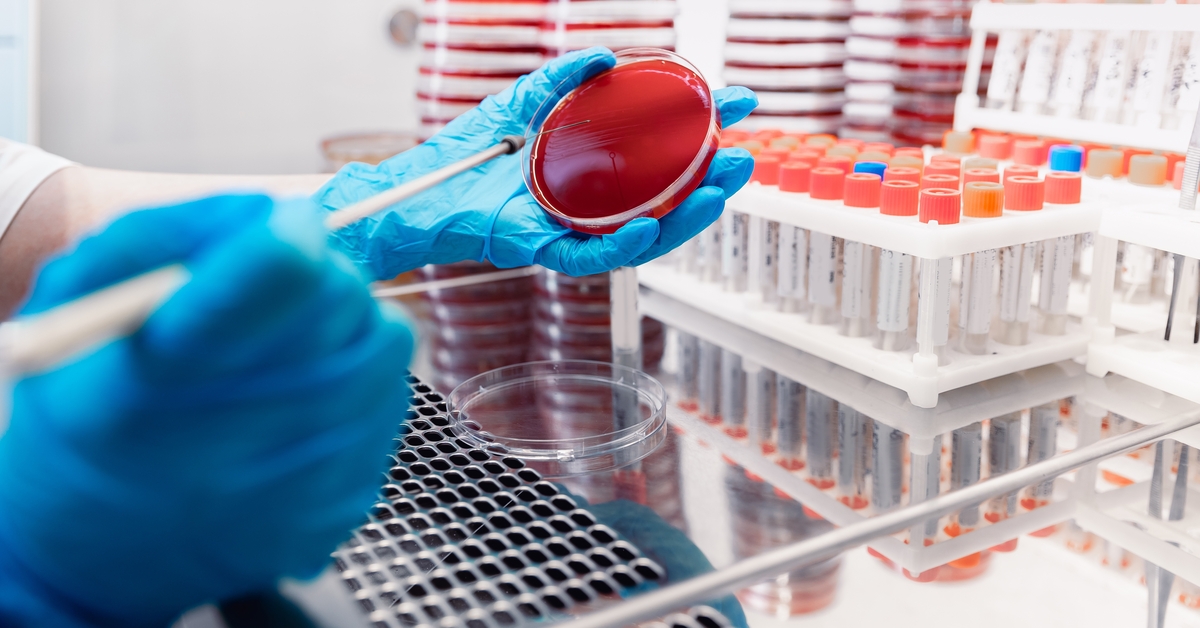

Haber
-

Sağlık Bakanlığı “bebek ölümlerinin önlenemez olduğuna dair rapor sunulduğu” iddiasını yalanladı
Bakanlığın “Sağlık Bakanlığı Sağlıklı Çözüm” adlı sosyal medya hesabından, “Yenidoğan çetesi yargılaması kapsamında Sağlık Bakanlığınca bebek ölümlerinin önlenemez olduğuna dair…
Daha Fazlasını Oku » -
Menenjit vakalarındaki artış ürkütüyor
Yaklaşık 20 yıldır erişkinde meningokok menenjiti görmediğini kaydeden Yılmaz, bu hastalığın çocukluk yaş grubunda sıkça görülebildiğini ancak erişkin yaş grubunda…
Daha Fazlasını Oku » -

Emzirirken fazla kafein almak bebekte kansızlık yapıyor
Kafeinin uyanıklık, dikkat ve enerji seviyelerini artıran etkilerinin, emziren anneler için önem taşıdığını söyleyen Tıbbi Biyokimya Anabilim Dalı Öğretim Üyesi…
Daha Fazlasını Oku » -

Ahmet Nur Çebi Fikret Orman’a fena salladı
Beşiktaş’ın eski başkanı Ahmet Nur Çebi, Divan Kurulu Toplantısı’nda Hasan Arat ve Fikret Orman’a sert eleştirilerde bulundu. Çebi, Fikret Orman’a…
Daha Fazlasını Oku » -
YAZARLIK KARİYERİNDEKİ BAŞARISININ ÖDÜLLERLE TAÇLANDIRILDIĞI DOÇ. DR. TUĞHAN TURAN HABERİMİZDE…
Doç. Dr. Tuğhan Turan, 2024 yılının son çeyreğinde SATIŞ SERBEST isimli kişisel gelişim kitabını yayımlamıştı. O günden bu yana geçen…
Daha Fazlasını Oku » -

Tekirdağ’da sahile köpek balığı vurdu
Şarköy ilçesi sahilinde yürüyüş yapanlar, sahilde ölü köpek balığı olduğunu görünce durumu yetkililere bildirdi. Bölgeye gelen ilçe belediyesinden ekipler köpekbalığını…
Daha Fazlasını Oku » -

Türk kadın pilot gururlandırdı: Dünyanın en büyük uçağının kontrolü artık onda!
Türk kadınlarının gökyüzündeki başarılarına bir yenisi eklendi. Dünyanın en büyük yolcu uçağı Airbus A380’de ikinci pilot olarak görev yapan Yıldırım,…
Daha Fazlasını Oku » -

Geçen yıl 224 futbol sahası büyüklüğünde hayalet ağ çıkarıldı
2014 yılından beri balıkçılık faaliyetlerinde kaybolan veya terk edilen av araçlarının sucul ekosistemden temizlenmesi amacıyla Hayalet Ağ Projesi (HAP) uygulanıyor.…
Daha Fazlasını Oku » -

Türkiye nasıl Avrupa’nın çöplük merkezi haline geldi? Zehirli çöp yığınları Türkiye’de
Sözcü TV Dış Haberler Müdürü Burak Tatari, Türkiye’nin ithal ettiği çöplerin doğaya, insanlara olan zararını anlattı. Tatari Guardian’da yayımlanan “Türkiye,…
Daha Fazlasını Oku » -

Kerem Demirbay’dan yabancı hakem sorusuna 3 kelimelik yanıt
Ziraat Türkiye Kupası’nda Galatasaray ile Konyaspor’un golsüz berabere kalmasının Yatırımsız deneme bonusu ardından Galatasaraylı futbolculara “Yabancı hakem mi, Türk hakem…
Daha Fazlasını Oku »